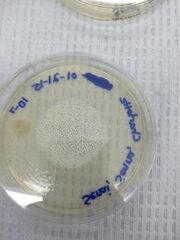
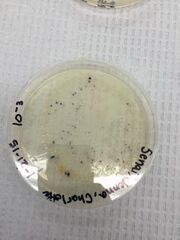

Uploads by Charlotte Raley
From OpenWetWare
Jump to navigationJump to search
This special page shows all uploaded files.
| Date | Name | Thumbnail | Size | Description |
|---|---|---|---|---|
| 23:39, 22 March 2015 | Zebrafish10.jpg (file) |  |
121 KB | |
| 23:37, 22 March 2015 | Zebrafish9.jpg (file) |  |
160 KB | |
| 23:20, 22 March 2015 | 20150322 185953.jpg (file) |  |
186 KB | |
| 23:19, 22 March 2015 | Zebrafish8.jpg (file) |  |
186 KB | |
| 22:06, 18 February 2015 | BIOIS.jpg (file) |  |
27 KB | |
| 22:05, 18 February 2015 | BIOFC.jpg (file) |  |
97 KB | |
| 21:32, 18 February 2015 | BIOTE.jpg (file) |  |
69 KB | |
| 21:32, 18 February 2015 | BIOSP.jpg (file) |  |
73 KB | |
| 21:31, 18 February 2015 | BIONE.jpg (file) |  |
99 KB | |
| 21:31, 18 February 2015 | BIOHO.jpg (file) |  |
58 KB | |
| 21:20, 18 February 2015 | BIOCH1.jpg (file) |  |
272 KB | |
| 21:18, 11 February 2015 | BIOasco.jpg (file) |  |
39 KB | |
| 21:14, 11 February 2015 | BIOmush.jpg (file) |  |
43 KB | |
| 21:12, 11 February 2015 | BIOrhi.jpg (file) |  |
74 KB | |
| 05:03, 11 February 2015 | Bio55.jpg (file) |  |
78 KB | |
| 19:01, 9 February 2015 | Transect Sample Plants.pdf (file) | 209 KB | ||
| 21:38, 4 February 2015 | BIO93.jpg (file) |  |
13 KB | |
| 21:37, 4 February 2015 | BIO92.jpg (file) |  |
16 KB | |
| 21:37, 4 February 2015 | BIO91.jpg (file) |  |
14 KB | |
| 21:37, 4 February 2015 | BIO90.jpg (file) |  |
16 KB | |
| 19:27, 4 February 2015 | BIO11.jpg (file) |  |
95 KB | |
| 18:51, 4 February 2015 | BIO9.jpg (file) |  |
175 KB | |
| 07:30, 4 February 2015 | BIOCHART.jpg (file) |  |
314 KB | |
| 07:22, 4 February 2015 | Bio Dilutions Chart.docx (file) | 49 KB | ||
| 07:15, 4 February 2015 | BIO3.jpg (file) |  |
10 KB | |
| 07:10, 4 February 2015 | BIO2.jpg (file) | |
11 KB | |
| 07:07, 4 February 2015 | BIO1.jpg (file) |  |
10 KB | |
| 07:02, 4 February 2015 | BIO.jpg (file) | |
10 KB | |
| 01:30, 30 January 2015 | Bio Chart.docx (file) | 13 KB |